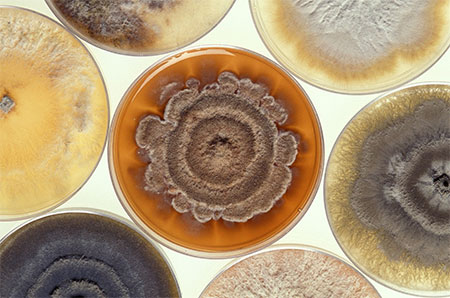
How To Stay On Top Of Mold with AWA Environmental

How To Stay On Top Of Mold with AWA Environmental
Mold is able to wreak havoc on your health and cause problems that are extremely severe.
18/07/2019
While mold can be unsightly, this is not the only problem that it brings. Mold is able to wreak havoc on your health and cause problems that are extremely severe. The problem is that homes are usually the ideal environment for mold.
It is possible to have mold in every room of your home. Fortunately, there are some key areas that you should look at when it comes to staying on top of the mold in your home.
Look At The Washing Machine
Washing machines are for cleaning and it can seem strange that this would be a place for mold to thrive. The problem is that mold generally starts in the areas that you cannot see. The washing machine is a great example of this.
When you start to consider the facts, this is not that surprising. Your washing machine is heavily reliant on water and mold needs water. The question is what you can do to ease this problem.
The best step to take is to dry around the gasket and door after each use. There are some people who also run a bleach cycle once a month to kill the mold. There are further problems that could also occur which need additional work.
The Walls And Ceiling Of Your Bathroom
The walls and ceiling of your bathroom will be one of the most common places for mold. This is particularly true if your bathroom has a shower. In these cases, mold can quickly spiral out of control.
The reasons for this are fairly simple. The moisture content in the room will become too much to handle and mold will start to develop. This will happen on the first thing that the mould attaches itself too which is generally the walls and ceiling.
This will often happen when your bathroom does not have proper ventilation. This is why you need to look at an extraction fan for your bathroom. You should use the fan when you are showering and for approximately 30 minutes after the shower to remove the moisture. When you do this, you will find that the mold situation in the room starts to ease.
Indoor Plants Are A Source
A lot of people add plants to their living space with the best intentions in mind. The problem is that when you do not keep on top of your plants, you will be asking for trouble in terms of mold. If you water your plants too much, mould will be the result. Plants can also be a great place for mold to grow when the general humidity in your home is not correct for them.
Check The Fireplace
During the heart of winter, your fireplace is great. The problem comes when you are not actively using the fireplace because it can be a hive for mold. The ideal conditions for mould will be an area that is damp and cold.
The fact that the fireplace bricks are generally porous only adds to this. The porous nature of the brick means that mold can spread quickly if you do not take action.